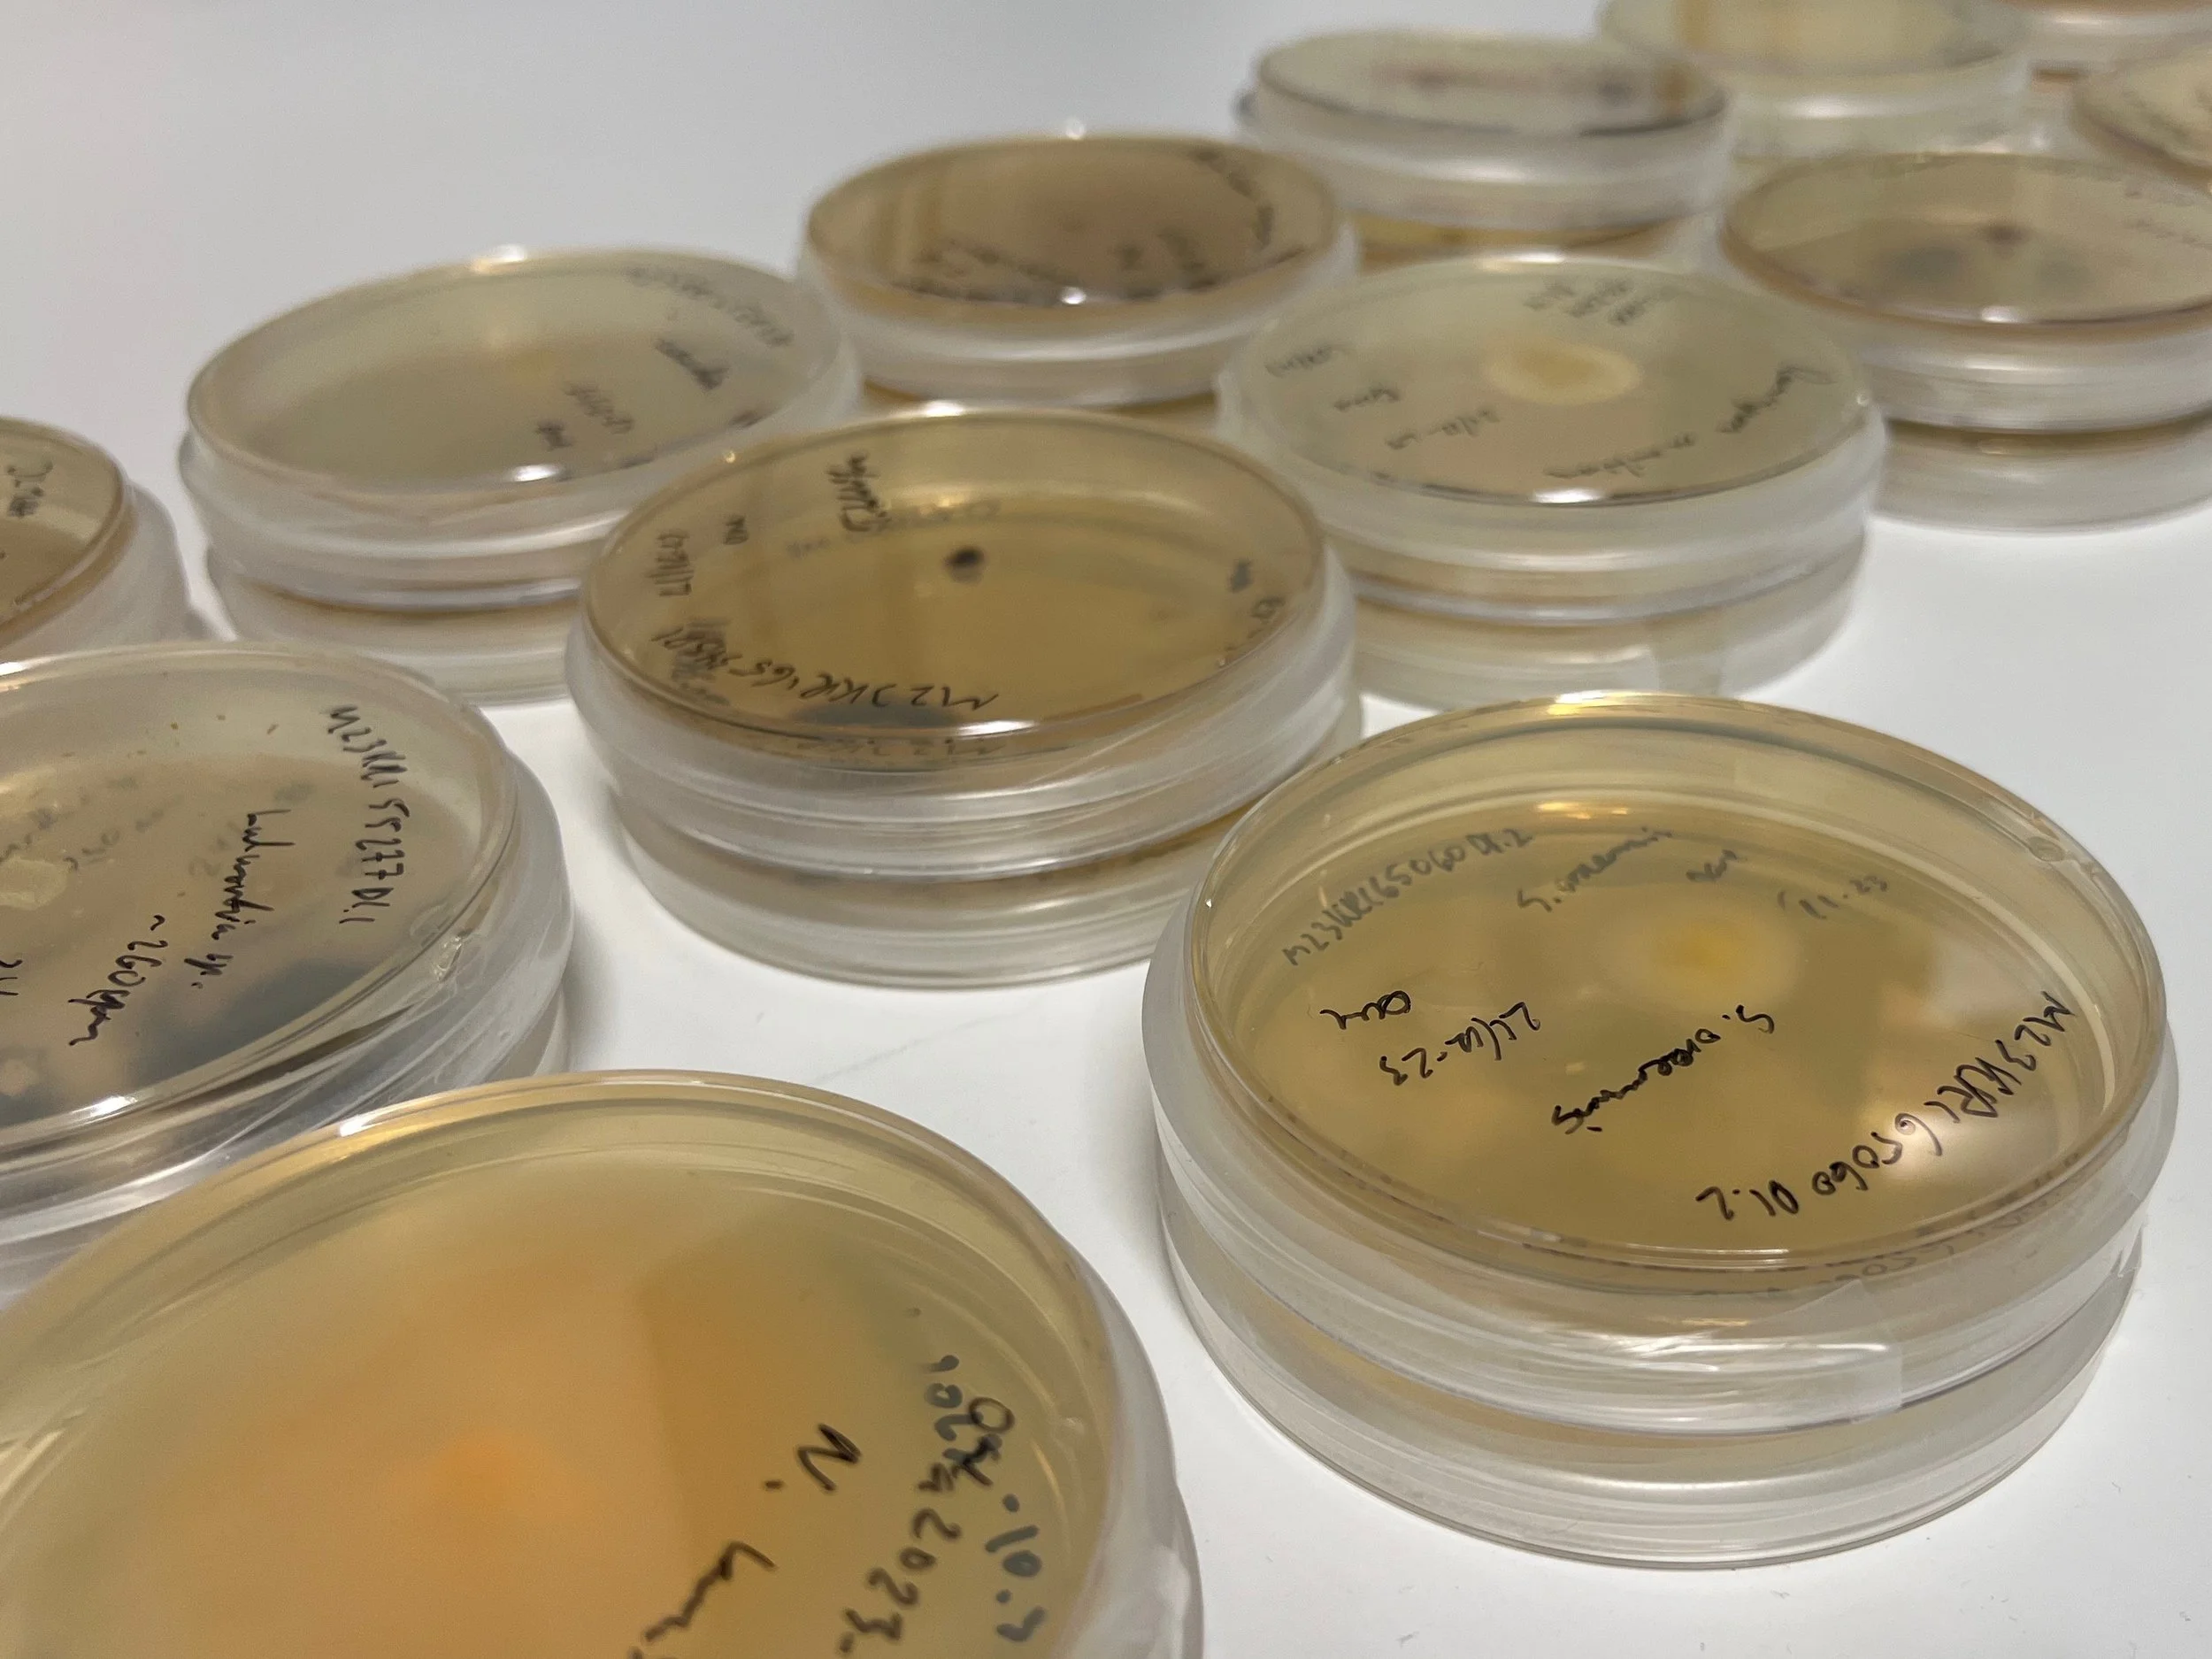

The HotBio Doctoral Network consists of 11 individual research projects that are interconnected in a modern biodiscovery pipeline. Click on the projects to learn more about the individual PhD candidates in the network and what the objectives of their research projects are.